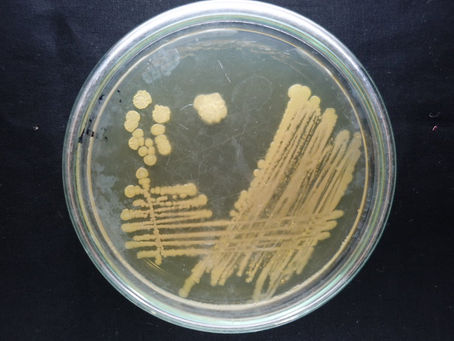
Bacillus megaterium in phosphorus solubilization

top of page
All Posts

Bacillus megaterium in phosphorus solubilization
Bacillus megaterium is a well‑documented phosphate‑solubilizing bacterium (PSB) that mobilizes inorganic and organic P and can also enhance availability of several micronutrients under a wide range of soil conditions. Bacillus megaterium_petri_colony_solubilizing phosphorous_XL Mechanisms of phosphorus solubilization Organic acid production : B. megaterium secretes low‑molecular‑weight organic acids (e.g. gluconic, citric, lactic acids), which chelate cations (Ca, Fe, Al) and

agridaeus
Feb 184 min read
bottom of page
